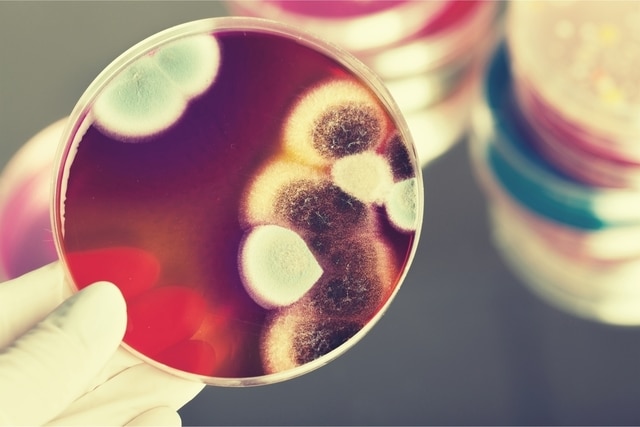

A Secretaria de Estado de Saúde informa que recebeu notificação de Provável caso de mucormicose, também conhecido como Fungo Negro, em paciente detectado para Covid-19 em Campo Grande-MS.
O Centro de Informações Estratégicas de Vigilância em Saúde (CIEVS) foi notificado em nesta segunda-feira (31.5) recebeu a notificação do CIEVS Campo Grande, sobre o Paciente C.E.D.S., 71 anos, residente de Campo Grande, com comorbidades Diabetes Mellitus e Hipertensão Arterial Sistêmica. Histórico de Síndrome Respiratória Aguda Grave, com início de sintomas em 09/05/2021. Em 18/05/2021 realizou RT-PCR detectável para Covid-19, sintomas febre, dor de garganta, dispneia, desconforto respiratório, saturação O2<95%, fadiga, anosmia e ageusia.
Admitido em UTI do serviço hospitalar no dia 18/05/2021 por SRAG. Foi imunizado para Covid-19 em 23/03 e 23/04/2021. Em 28/05 suspeita de mucormicose no olho esquerdo com equimose palpebral intensa e lesão necrótica superior poupando a borda, apresentando quemose conjuntival sanguinolenta e úlcera corneana. Evolução clínica: paciente em V.M., instável hemodinamicamente, sem condições para transferência para instituição de maior complexidade
O termo mucormicose é usado para se referir a toda infecção fúngica causada por fungo da classe Zygomycetes e ordem Mucorales. As pessoas contraem mucormicose entrando em contato com os esporos fúngicos no ambiente. Por exemplo, as formas pulmonares ou sinusais da infecção podem ocorrer depois que alguém respira em esporos. Essas formas de mucormicose geralmente ocorrem em pessoas que têm comorbidades ou utilizam medicamentos que diminuem a capacidade do corpo de combater algumas doenças.
A progressão da doença leva a uma sequência de sintomas que se iniciam com dor orbital unilateral ou facial súbita, podendo conter obstrução nasal e secreção nasal necrótica. Há a possibilidade de ocorrer lesão lítica escura na mucosa nasal ou dorso do nariz, celulite orbitária e facial, febre, ptose palpebral, amaurose, oftalmoplegia, anestesia de córnea, evoluindo em coma e óbito.
O tratamento envolve remover cirurgicamente todos os tecidos mortos e infectados. Em alguns pacientes, isso pode resultar em perda da mandíbula superior ou às vezes até mesmo do olho. A cura também pode envolver de 4 a 6 semanas de terapia antifúngica intravenosa. Como afeta várias partes do corpo, o tratamento requer uma equipe de microbiologistas, especialistas em medicina interna, neurologistas intensivistas, oftalmologistas, dentistas, cirurgiões e outros.